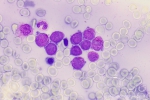
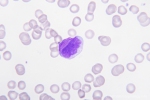

Demo page 3: APL with PML-RARA
APL typically have a low white cell count and only rare leukemic cells in the peripheral blood.
Bone marrow often is hard to aspirate, and show atypical promyelocytes; a high nucleus to cytoplasmic ratio, fine to medium coarse chromatin with prominent nucleoli. In some of the promyelocytes the cytoplasm contains densely-packed bright pink, reddish-blue, or dark purple granules, or multiple Auer rods (faggot-cells).
The cells commonly do not express CD34, HLA-Dr and CD11b, but are strongly expressing MPO, CD13 and CD33.